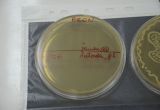
_DSC2600
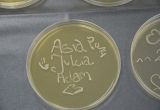
_DSC2601
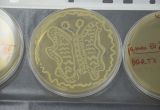
_DSC2604
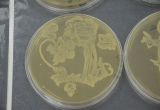
_DSC2605
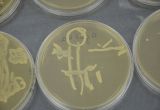
_DSC2606
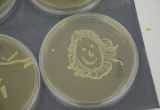
_DSC2607
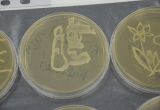
_DSC2609
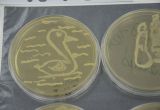
_DSC2610
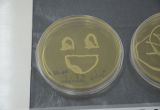
_DSC2613

W ramach kampanii promocyjnej Europejskiej Nocy Naukowców FUSION NIGHT, która odbędzie się 26 września 2014 r. przy ul. Bydgoskiej, młodzi adepci nauki mieli okazję wziąć udział w pokazach i interaktywnych eksperymentach, które pozwoliły im lepiej zrozumieć jak wielkie znaczenie mają osiągnięcia nauki w naszym codziennym życiu i jak fascynująca może być praca badacza. Przez cały czerwiec br. ponad 300 dzieci z 6 olsztyńskich szkół i przedszkoli mogło odrywać tajniki biologii i chemii pod okiem Pani mgr Joanny Fotschki i Pana mgr Justyna Wojtasika z IRZiBŻ PAN. (więcej…)
W ramach kampanii promocyjnej Europejskiej Nocy Naukowców FUSION NIGHT, która odbędzie się 26 września 2014 r. przy ul. Bydgoskiej, młodzi adepci nauki mieli okazję wziąć udział w pokazach i interaktywnych eksperymentach, które pozwoliły im lepiej zrozumieć jak wielkie znaczenie mają osiągnięcia nauki w naszym codziennym życiu i jak fascynująca może być praca badacza. Przez cały czerwiec br. ponad 300 dzieci z 6 olsztyńskich szkół i przedszkoli mogło odrywać tajniki biologii i chemii pod okiem Pani mgr Joanny Fotschki i Pana mgr Justyna Wojtasika z IRZiBŻ PAN. (więcej…)

18. Piknik Naukowy w Warszawie – fotorelacja

Jak ubiec epidemię wirusa ptasiej grypy, jak działa zegar biologiczny komórek i jak zatrzymać życie w czasie – tego m.in. dowiedzieli się goście 18. Pikniku Naukowego w Warszawie, którzy 31 maja odwiedzili stanowiska Instytutu Rozrodu Zwierząt i Badań Żywności PAN. Tematem przewodnim tegorocznego pikniku – organizowanego przez Centrum Nauki Kopernik (CNK) i Polskie Radio – był „Czas”. (więcej…)

18. Piknik Naukowy Polskiego Radia i Centrum Nauki Kopernik
 31 maja na Stadionie Narodowym w Warszawie odbędzie się XVIII Piknik Naukowy Polskiego Radia i Centrum Nauki Kopernik. Zapraszamy do odwiedzenia stoiska Instytutu w namiocie nr A32 oraz stojącego obok naszego Laboratorium mobilnego.
31 maja na Stadionie Narodowym w Warszawie odbędzie się XVIII Piknik Naukowy Polskiego Radia i Centrum Nauki Kopernik. Zapraszamy do odwiedzenia stoiska Instytutu w namiocie nr A32 oraz stojącego obok naszego Laboratorium mobilnego.
Nasze pokazy nawiązywać będą do tegorocznego hasła Pikniku „Czas”. Przybliżymy procesy starzenia się komórek rozrodczych. Zaprezentujemy również bioczujniki do bardzo szybkiego wykrywania wirusów „ptasiej grypy” H5N1. Natomiast w Laboratorium mobilnym „zatrzymamy życie w czasie” i pokażemy jak w tym celu wykorzystuje się ciekły azot .
Więcej informacji na www.pikniknaukowy.pl

IRZiBŻ od kuchni

 8 maja br. Instytut Rozrodu Zwierząt i Badań Żywności PAN otworzył swoje podwoje dla wszystkich tych, którzy chcieli zobaczyć jak wygląda praca olsztyńskich naukowców w niedostępnych na co dzień laboratoriach placówki wyróżnionej przez MNiSW najwyższą kategorią A+ . (więcej…)
8 maja br. Instytut Rozrodu Zwierząt i Badań Żywności PAN otworzył swoje podwoje dla wszystkich tych, którzy chcieli zobaczyć jak wygląda praca olsztyńskich naukowców w niedostępnych na co dzień laboratoriach placówki wyróżnionej przez MNiSW najwyższą kategorią A+ . (więcej…)
Dni Otwarte Instytutu – 8 maja 2014

Instytut Rozrodu Zwierząt i Badań Żywności serdecznie zaprasza na Dni Otwarte, które odbędą 8 maja br. w Oddziale Nauk o Żywności (ul. Tuwima 10) w godz. 9:00-15:00.
Mieszkańcy Warmii i Mazur będą mieli wyjątkową okazję odwiedzenia, niedostępnych na co dzień, laboratoriów Instytutu i sprawdzenia jak badania, projekty i przedsięwzięcia realizowane przez naukowców dzięki Funduszom Europejskim wpływają na podniesienie jakości życia społeczeństwa oraz rozwój innowacji w regionie.
Informacje o Dniu Otwartym w serwisie PAP Nauka w Polsce.

Dni Otwarte Instytutu – FOTORELACJA
Zapraszamy do obejrzenia galerii zdjęć z Dni Otwartych Instytutu Rozrodu Zwierząt i Badań Żywności PAN, które odbyły się w Oddziale Nauk o Żywności 27 września 2013.
Naukowcy z wizytą u małych pacjentów

Naukowcy z Instytutu Rozrodu Zwierząt i Badań Żywności PAN w Olsztynie zagoszczą we wtorek (14 lipca) w Olsztyńskim Zespole Szkół Specjalnych z popularno-naukowymi warsztatami, pokazami i eksperymentami. (więcej…)

Dni otwarte Instytutu
 27 września w ramach 11 Olsztyńskich Dni Nauki i Sztuki Instytut Rozrodu Zwierząt i Badań Żywności PAN po raz kolejny otworzy swoje drzwi dla młodych naukowców z olsztyńskich szkół.
27 września w ramach 11 Olsztyńskich Dni Nauki i Sztuki Instytut Rozrodu Zwierząt i Badań Żywności PAN po raz kolejny otworzy swoje drzwi dla młodych naukowców z olsztyńskich szkół.
W godzinach 9-12 uczniowie będą mogli odwiedzić wybrane laboratoria, w których prowadzone są badania nad m.in. otyłością, regeneracją tkanek, a także dowiedzieć się w jaki sposób niekorzystne czynniki środowiska wpływają na komórki rozrodcze. Pokażemy również etapy wyrobu dietetycznego chleba. (więcej…)
Europejska Noc Naukowców – podsumowanie
Teleexpress extra
TVP Olsztyn Opinie
TVP Olsztyn Informacje (15:15)
TVP Olsztyn Informacje (19:30)
Zakończyła się Europejska Noc Naukowców w Olsztynie Fusion Night. Ponad 10 tysięcy uczestników popularno-naukowych warsztatów, wykładów, eksperymentów i pokazów to bilans, który potwierdza tezę, że nauka ma ogromną moc przyciągania.
Na odwiedzających czekało ponad 70 spotkań z nauką, podczas których dzieci, młodzież, a także dorośli mogli wejść do niedostępnych na co dzień laboratoriów Instytutu Rozrodu Zwierząt i Badań Żywności PAN i pracowni Olsztyńskiej Szkoły Wyższej im. Józefa Rusieckiego.
Goście Fusion Night mieli okazję „wziąć naukę w swoje ręce” i w specjalnie przygotowanym bloku tematycznym NIE BÓJ SIĘ EKSPERYMENTOWAĆ sprawdzić m.in. jak zamknąć słońce w próbówce i wywołać w niej burzę (Fusion lab), jak skomponować swój własny krem z dodatkiem sproszkowanych owoców (Smakowita skóra), oraz jak samodzielnie określić zawartość antyoksydantów w naszych ulubionych sokach (Zobacz antyoksydanty).
Noc Naukowców w Olsztynie była także okazją aby PRZYJŚĆ PO ZDROWIE i wziąć udział w różnego rodzaju testach na naszą sprawność fizyczną, m.in. podczas pokazów Jak gibkie jest moje ciało, Postaw się a zbadaj się, Czy moja prawa noga jest silniejsza od lewej? Ponadto, każdy dorosły uczestnik pokazów mógł samodzielnie wykonać test na celiakię, czyli nietolerancję glutenu oraz wysłuchać wykładu pt. Celiakia? Czy na pewno mi to nie grozi? Podczas warsztatów Mikrokosmos na talerzu goście Fusion Night nie tylko obejrzeli bakterie pod mikroskopem, ale też przekonali się, że są one wdzięcznym materiałem do malowania.
Nie lada gratką nie tylko dla dzieci ale też dla dorosłych okazała się wyjątkowa możliwość POZNANIA CUDÓW TECHNOLOGII „od kuchni”. Partnerzy Fusion Night, firmy Michelin Polska i Mir-Wit Toyota, zaprezentowały technologie przyszłości – Hybrydowe Silniki i Innowacyjne metody produkcji opon. Podczas Pokazu Druku z Zortraxem zwiedzający mogli zagrać na wydrukowanym w technologii 3D ukulele i zobaczyć proces powstawania takich przedmiotów od podstaw. Ogromnym zainteresowaniem cieszyło się również Mobilne Kino 5D, w którym każdy mógł poczuć efekty specjalne z filmów na własnej skórze.
Cykl SPOTKAŃ Z NAUKOWCAMI „PO GODZINACH” pomógł przełamać stereotyp badaczy, postrzeganych jako nudnych, skupionych wyłącznie na swojej pracy i zamkniętych w laboratoriach, i pozwolił zobaczyć ich jako pasjonatów odkrywania, ludzi o inspirujących osobowościach i często nietuzinkowych zainteresowaniach (Naukowiec wysokich lotów, Tkanki na szkle, Poznaj naukowca z pasją, Samotny spacer – Camino de Santiago w obiektywie naukowca). Takie spotkania są znakomitą okazją do pokazania szczególnie młodym ludziom jak fascynująca i satysfakcjonująca może być praca badacza, a także do zachęcenia ich do rozważenia w przyszłości kariery naukowej.
W programie Fusion Night znalazło się też sporo atrakcji dla miłośników zwierząt. Uczestnicy wykładów Dzika strona natury i Biologiczny misz masz wokół nas poznali badania prowadzone w Instytucie, zmierzające do ochrony bioróżnorodności i gatunków zwierząt narażonych na wyginięcie. Podczas warsztatów Zbuduj dom dla czworonoga całe rodziny budowały innowacyjne psie budy i kocie piętrowe domki, które następnie trafiły do Olsztyńskiego Schroniska dla Bezdomnych Zwierząt.
Noc Naukowców w Olsztynie zachęcała też aby WYTĘŻAĆ SWÓJ UMYSŁ I WYGINAĆ CIAŁO. Podczas pokazu Generatora van de Graaffa można było się dowiedzieć dlaczego przy zdejmowaniu swetra słychać trzaski i jak przesuwać przedmioty na odległość dzięki wyładowaniom elektrostatycznym. Entuzjaści sportu mogli z kolei obejrzeć mecz koszykówki na wózkach, a także wziąć udział w kursie salsy i zajęciach aqua aerobicu.
Specjalne atrakcje czekały tez na uczestników warsztatów w bloku tematycznym ZBADAJ SWOJĄ KOMÓRKĘ. Podczas pokazu Dowody zbrodni można było sprawdzić jak DNA wykorzystywane jest w badaniach kryminalistycznych, a podczas wizyty w Mobilnym Laboratorium Kriokonserwacji Komórek dowiedzieć się dlaczego gamety określa się mianem żywych pocisków.
Wieczorem na uczestników Nocy Naukowców czekał koncert Grzegorza Turnaua, występ kabaretu SMILE i pokaz Kuchni Molekularnej Fusion Kitchen.
Olsztyn był jednym z 9 miast w Polsce i 300 w Europie organizujących tegoroczną edycję Europejskiej Nocy Naukowców. Już teraz zapraszamy wszystkich na 10. Jubileuszową Noc w przyszłym roku.